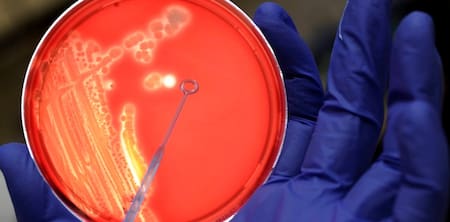
Bacterias en análisis de la Escherichia coli. Foto: EFE

Dónde y cómo guardar la lechuga para conservar sus beneficios y que no perjudique la salud

Las verduras más utilizadas por las personas, que contienen nutrientes y que aportan fibras, son las de hojas verdes. Para una alimentación saludable y completa es necesario ingerir una amplia variedad de alimentos, entre ellos la lechuga.
Entre los beneficios que tiene esta verdura, aporta vitamina A, calcio, hierro y ácido fólico, que permite fortalecer el sistema inmunológico. Sin embargo, si esta verdura no se guarda ni se lava correctamente, puede generar bacterias que podrían ocasionar graves problemas de salud.

La lechuga debe ser lavada correctamente. Foto: Unsplash.
Según un estudio publicado en University of Illinois College of Agricultural, Consumer and Environmental Sciences, las verduras, como la lechuga, se deben guardar en la heladera para que no se reproduzcan los microbios peligrosos.
También podría interesarte
El resultado de la investigación brindó que, si se guarda a 4 °C, la presencia de la bacteria Escherichia coli (E.coli) se reduce. En cambio, si se deja a temperatura ambiente se expanden a gran medida.
Las enfermedades que provoca la bacteria E.coli
Este germen, que puede estar presente en el agua o en alimentos contaminados como vegetales crudos, puede provocar síntomas como diarrea, calambres estomacales, náuseas y vómitos, entre otros, según detalló el artículo de Mayo clinic.
Bacterias en análisis de la Escherichia coli. Foto: EFE.
Esto ocurre por la liberación de una toxina que afecta al intestino delgado. La infección puede generarse incluso al comer pequeñas porciones de algún alimento infectado por la Escherichia coli.
Cómo prevenir la bacteria
Si bien no hay remedio o algún tipo de vacuna para protegerse de la E.coli, si hay prevenciones para implementar en la rutina diaria.
- Lavar las manos con frecuencia.
- Evitar alimentos peligrosos.
- No tragar agua en piletas.
- Ingerir agua segura.
- Separar los alimentos crudos.
- Limpiar los utensilios luego del contacto con este tipo de comidas.